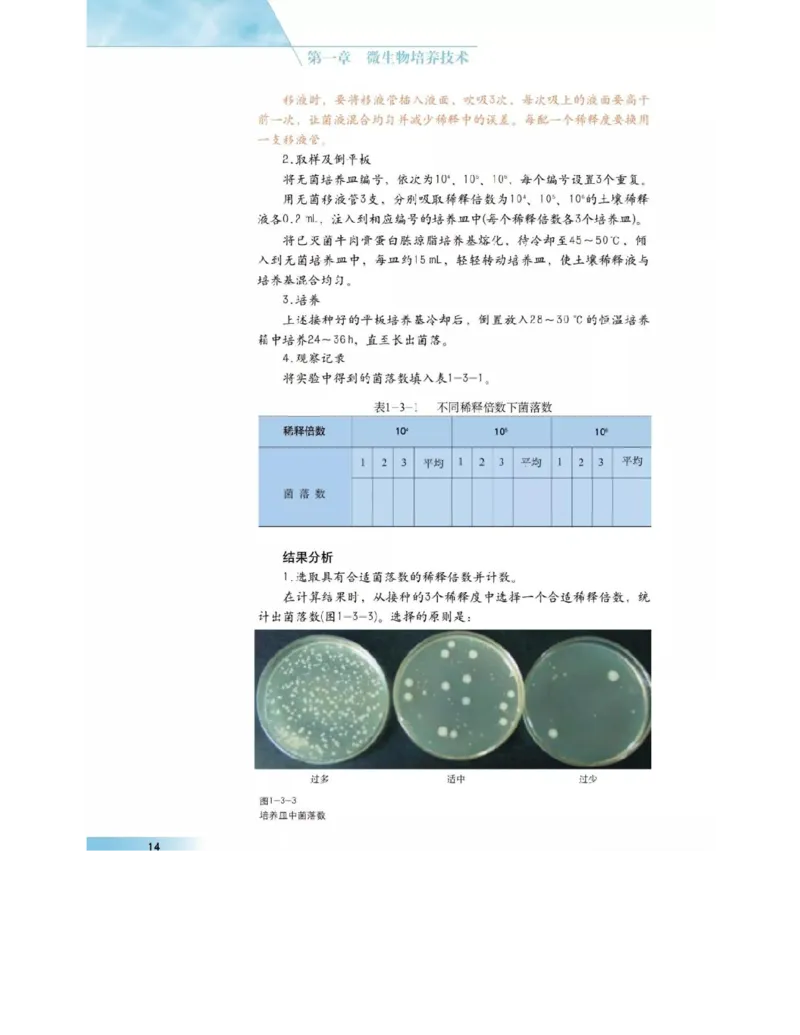
沪科版高中生物选修1《生物技术实践》电子课本_4-教培资料-26年最新资料-同步更新_初中高中教资_03科三专项（进去保存报考的学科即可）_112025高中科目（全）电子教材

沪科版高中生物选修1《生物技术实践》电子课本_4-教培资料-26年最新资料-同步更新_初中高中教资_03科三专项(进去保存报考的学科即可)_112025高中科目(全)电子教材
- 2026-06-04 04:17:00 2026-02-08 13:52:34
文档预览

本文档来自网络内容,如有侵犯您的权益请联系我们删除,联系邮箱:wyl860211@qq.com。
